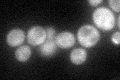
YJL087C
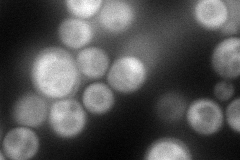
YJL087C
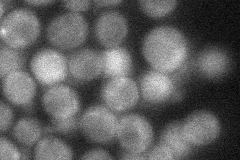
YJL087C
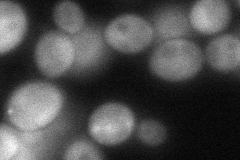
YJL087C
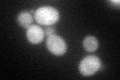
YJL087C

View description
tRNA ligase, required for tRNA splicing; composed of three essential domains containing the phosphodiesterase, polynucleotide kinase, and ligase activities required for ligation; localized at the inner membrane of the nuclear envelope
Localization:
Intensity:
Fold change:
Significance:
-
C’ GFP library in SD
cytosol41.33 -
N' NOP1pr-GFP in SD
cytosol112.577 -
N' TEF2pr-mCherry in SD

cytosol118.422 -
N' NATIVEpr-GFP in SD
cytosol35.7626 -
N' TEF2pr-VC and Cyto-VN in SD
cytosol64.4623 -
C’ GFP library in SD+DTT
cytosol42.021.01No -
C’ GFP library in SD+H2O2

cytosol42.771.03No -
C’ GFP library in Starvation Media

cytosol29.820.72No -
C’ GFP library on the background of Pup2-DaMP

cytosol -
C’ GFP library on the background of CCT mutant

cytosol44.83971.08472No
